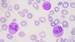
FDA Approves First Gene Therapy for Beta-Thalassemia

Patients with iron overload — serum ferritin > 1000 µg/L or a diagnosis of hemochromatosis or thalassemia — were 60% more likely to have an osteoporotic fracture during an up to 10-year follow-up than matched control patients, in a large study.
Compared with control patients, those with iron overload had a roughly twofold increased risk of a vertebral fracture, as well as an increased risk of a hip or humerus fracture, but not a forearm fracture.
The increased risk of fracture in men with iron overload (compared with other matched men) was greater than the increased risk of fracture in women with iron overload (compared with other matched women).
Andrea Burden, PhD, presented the findings during a late-breaking clinical science session last week at the American Society of Bone and Mineral Research (ASBMR) 2022 Annual Meeting.
"We Should Worry About the Bones as Well as the Liver"
Based on these results, clinicians should probably do earlier bone mineral density (BMD) determinations to screen for osteoporosis and perhaps consider prophylaxis with vitamin D and calcium, said Burden, assistant professor, Institute of Pharmaceutical Sciences, ETH Zurich, Switzerland.
"However, I say that with a bunch of caution," she added, "because we actually don't have much evidence of the impact of these treatment differences on fracture risk."
"This is the first large population study on this topic," although there have been a few case reports, Burden explained to Medscape Medical News in an interview.
However, "The high iron overload of > 1000 µg/L is not common, and hereditary hemochromatosis or thalassemia also are very rare," she noted.
"The study shows that once patients have an iron overload of more than 1000 µg/L, we need to be doing regular checks for their BMD and figuring how to best minimize their fracture risk."
"A twofold risk for a vertebral fracture" in patients with iron overload "is really high," she noted. It is known that men with iron overload have loss of testosterone, but it may be less well known that they have an increased fracture risk.
"We worry about the liver," she said, "not so much about the bones, and this shows us that we really should."
Session co-moderator Michael J. Econs, MD, who was not involved with the research, agrees. "Iron overload does occur, and it is a clinically important problem and can lead to hemochromatosis, which can lead to a whole host of diseases, but the most common is liver disease," he told Medscape Medical News.
"So, it is a clinically important problem, not only in people who are genetically predisposed but in people who get frequent transfusion," said Econs, distinguished professor of medicine and medical and molecular genetics at Indiana University, Indianapolis.
Now this new study has found an increase in fractures in such people, he noted.
Large Case-Control Study Used UK Database
Using data from the IQVIA Medical Research Database, researchers identified 21,166 iron overload patients aged 18 years and older who saw a general practitioner in the UK between 2010 and 2020 and had a serum ferritin level above 1000 µg/L or a diagnostic code for hemochromatosis or non-anemic thalassemia.
They matched each iron overload patient with up to 10 control patients based on age, sex, year, and general practitioner, for a total of 198,037 control patients.
Patients were a mean age of 59 years and 59% were men.
During follow-up there were 777 fractures in the iron-overload patients (9.61 fractures per 1000 patient-years) and 4344 fractures in the control group (4.68 fractures per 1000 patient-years).
In adjusted hazard ratio (aHR) models, researchers adjusted for age, sex, body mass index, alcohol, smoking, history of fractures earlier than 365 days prior to study entry, hypogonadism, osteoporosis, medications, and comorbidities.
Overall, patients in the iron overload group had a 60% higher risk of an osteoporotic fracture (aHR, 1.60).
Among women, the incidence of osteoporotic fracture was 12.63 per 1000 patient-years in the iron overload group and 7.09 per 1000 patient-years in the control group.
Women with iron overload had a 48% higher risk of osteoporotic fracture compared with other women (aHR, 1.48).
Among men, the incidence of osteoporotic fracture was 6.71 per 1000 patient-years in the iron overload group and 3.01 per 1000 patient-years in the control group.
Men with iron overload therefore had an 82% higher risk of osteoporotic fracture compared with other men (aHR, 1.82).
Compared to patients without iron overload, patients with iron overload had an increased risk of a vertebral (aHR, 2.18), hip (aHR, 1.60), and humerus (aHR, 1.82) fracture but not a forearm fracture.
The researchers acknowledge that study limitations include they did not look at phlebotomy or changes in ferritin levels, and they excluded patients with hereditary hemochromatosis diagnosed before age 18.
The work was funded by the German Research Foundation. One of the researchers has reported receiving an independent grant from Pharmacosmos. The other researchers as well as Econs have reported no relevant financial relationships.
ASBMR 2022 Annual Meeting. Presented September 12, 2022. Abstract 1115.
For more diabetes and endocrinology news, follow us on Twitter and Facebook.
Credit: Angellodeco/Dreamstime
Medscape Medical News © 2022 WebMD, LLC
Send comments and news tips to news@medscape.net.
Cite this: High Iron Levels Predict Greater Fracture Risk, More So in Men - Medscape - Sep 21, 2022.

Comments